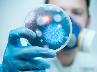

Loading...
![]()
|
4.8.2014
Молодожёны в Великобритании разглядывали старые семейные фотографии,
когда обнаружили, что впервые они повстречались 11 лет назад, играя на
пляже.
|
|

Loading...
![]()
|
4.8.2014
Британский индустриальный дизайнер Джош Ренуф изобрел гениальный
будильник. Вместо того, чтобы противно трезвонить по несколько раз и
заставлять тебя вылазить из кровати всеми
правдами и неправдами, он попросту варит чашку кофе как раз к времени
подъема.
|
|

Loading...
![]()
|
4.8.2014
В первые дни последнего летнего месяца, а именно 6-7 августа Федерация гимнастики Азербайджана проведет очередной объединенный турнир по гимнастике: спортивной, акробатической и тамблингу.
|
|

Loading...
![]()
|
4.8.2014
Медаль 3-й степени за "Отличие на военной службе" присвоена министром обороны Закиром Гасановым 37-летнему прапорщику Алмазову Исе Зияд оглу, ставшему шехидом при отражении вражеской атаки азербайджанской армией на передовой линии фронта.
|
|

Loading...
![]()
|
4.8.2014
В Пираллахинском районе Баку будет построен парк высоких технологий (YT
Park – YTP). Об этом сообщили в районной исполнительной власти (ИВ).
|
|

Loading...
![]()
|
1.8.2014
Последние несколько столетий физики и астрономы ломали голову над необычной формой естественного спутника Земли, однако найти этому правдоподобное объяснение им удалось лишь сейчас.
|
|

Loading...
![]()
|
1.8.2014
Жители всего мира смогут наблюдать суперлуние с 21:05 10 августа до 06:50 11 августа. Августовское суперлуние будет самым большим и ярким в году, отмечают астрономы.
|
|

Loading...
![]()
|
1.8.2014
В Азербайджане технический осмотр автомобилей зарубежного производства и моделей, выпускаемых на их базе в странах СНГ, продлен до 15 августа.
|
|

Loading...
![]()
|
1.8.2014
Ученые из Калифорнийского университета в Сан-Диего обнаружили неизвестный науке вирус, который присутствует в кишечнике у половины населения земного шара. Об этом сообщает Day.Az со ссылкой на FederalPost.
|
|

Loading...
![]()
|
1.8.2014
В Каспийском море сегодня ночью, в 01.29, было зарегистрировано землетрясение магнитудой 4,6.
|
|

Loading...
![]()
|
1.8.2014
Международная организация труда (МОТ) включила Азербайджан в список стран, которые проводят успешную политику в сфере обеспечения занятости молодежи.
|
|

Loading...
![]()
|
1.8.2014
Овен, 1 августа
Сегодня вам или кому-нибудь из ваших родных может придти в голову шальная мысль попереставлять мебель. Не надо!!!
|
|

Loading...
![]()
|
31.7.2014
Компания Apple обновила компьютеры Macbook Pro с Retina-дисплеем. Ноутбуки получили более быстрые процессоры и вдвое больший объем памяти в обеих моделях начального уровня, сообщает пресс-служба Apple.
|
|

Loading...
![]()
|
31.7.2014
Ученые из Шотландии пришли к выводу, что наша Галактика — Млечный путь — весит гораздо меньше, чем принято считать.
|
|

Loading...
![]()
|
31.7.2014
Сегодня Государственная Комиссия по Приему Студентов проведет экзамен по выявлению способностей для абитуриентов, желающих поступить на специальность журналистики на 2014/2015 учебный год.
|
|

Loading...
![]()
|
31.7.2014
Заслуженный деятель искусств Азербайджана, режиссер Зия Шихлинский приступает к съемкам документального фильма "Посвящение".
|
|

Loading...
![]()
|
31.7.2014
Студент Королевского колледжа искусств (Великобритания) Юлиан Мелкиорри разработал искусственный лист, способный выделять кислород, поглощая углекислый газ и воду.
|
|

Loading...
![]()
|
31.7.2014
По инициативе вице-президента Фонда Гейдара Алиева Лейлы Алиевой Азербайджанское молодежное объединение России (АМОР) совместно с Департаментом культуры города Москвы и при информационной поддержке «Aze Project» объявляет открытый фотоконкурс «Best summer photo of 2014. Azerbaijan» для фотографов-любителей.
|
|

Loading...
![]()
|
31.7.2014
Овен, 31 июля
Проведите этот день в стороне от каких-либо событий, насколько это будет возможно. Ваш выход будет чуть позже.
|
|
Loading...
![]()
|
30.7.2014
Овен, 30 июля
Сегодняшний день не слишком хорошо подходит для ведения переговоров и прочих деловых бесед, зато идеален для осуществления уже обговоренных задач. Чем и стоит заняться.
|
|